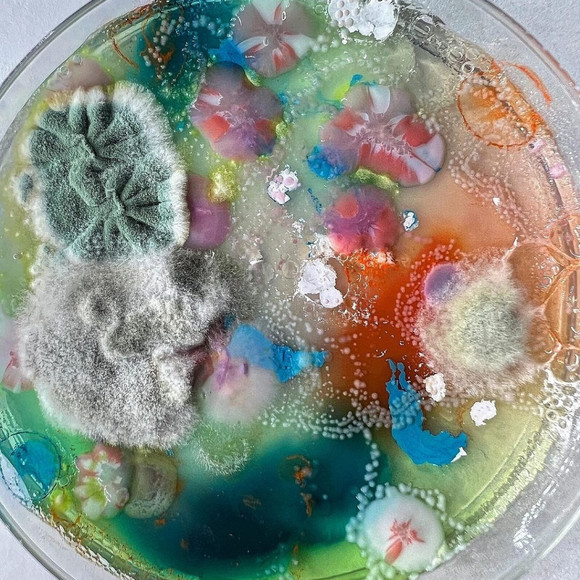
Meet your Posher, Emilija - Picture 1 of 1

Meet your Posher, Emilija
C$0
Size
Not for sale
Like and save for later
Hi! I'm Emilija. One of my favorite brands is Aritzia. Thanks for stopping by! Feel free to leave me a comment so that I can check out your closet too. :)
Shipping/Discount
Trending Now
Find Similar Listings
Account is under Review
Comment posting is temporarily restricted. Our team will reach out to you shortly. To understand why, select
Learn More.